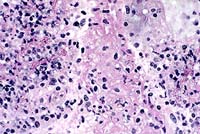

Results
AFIP Wednesday Slide Conference - No. 11
- 17 Dec 1997
Conference Moderator: LTC Michael J. Topper
Walter Reed Army Institute of Research
Division of Pathology
Washington, D.C. 20307
Return to WSC Case Menu.
Case I - 97-5000 (AFIP 2594818)
- Signalment: 1-year-old, female, sheep.
History: This animal was in good condition at the time
of slaughter.
Gross Pathology: There were several ovoid white nodules
(5-6 mm) projecting from the esophageal muscle.
Contributor's Diagnosis and Comments: Sarcocysts in esophageal
muscle.
Cause: Sarcocystis gigantea (ovifelis).
- There were macrocysts and few microcysts of Sarcocystis in
esophageal striated muscle fibers. Intact sarcocysts did not
incite an inflammatory reaction. Some degenerated cysts were,
however, surrounded by macrophages, epithelioid cells, lymphocytes
and collagen. There are four species of Sarcocystis in sheep.
Two of them are non-pathogenic macrocyst species producing grossly
visible cysts in muscles, particularly in the striated esophageal
musculature. They are Sarcocystis medusiformis and Sarcocystis
ovifelis, which have a sheep-cat cycle. The two microcysts species
that are potentially pathogenic are S. arieticanis and S. tenella,
which have a sheep-dog cycle. The microcysts are found in esophageal
and skeletal muscles, myocardium and brain.
-

Case 11-1. Esophagus. Sarcocystis gigantea with numerous
bradyzoites in muscle layer. A smaller cyst (immature or another
species) is adjacent to the larger one and the muscle fiber can
be identified. 2X
AFIP Diagnosis: Esophagus, tunica muscularis, skeletal
muscle: Protozoal cysts, multiple, with mild multifocal lymphoplasmacytic
to granulomatous myositis, breed unspecified, ovine, etiology
consistent with Sarcocystis gigantea.
Conference Note: As noted by the contributor, some of
the sections viewed in conference contained a degenerate cyst
surrounded by granulomatous inflammation.
Over 90 species of Sarcocystis have been recognized in mammals,
birds, and reptiles, and at least 14 of these are regularly found
in muscle of domestic animals.2 Often clinical disease does not
occur. The severity of clinical signs varies with the species
of parasite, the age of the infected animal, and the number of
sporocysts ingested. In lambs experimentally infected with varying
doses of S. tenella, effects included anemia, anorexia, decreased
weight gain, fever, and death.1 Spontaneous sarcocystosis in sheep
can present as a neurological disorder, affecting up to 10% of
a flock. Affected sheep show muscle weakness, hindlimb paresis,
and ataxia; some become recumbent, and occasionally sheep die
without any premonitory signs.1
All Sarcocystis species have an obligatory two-host life cycle.
Definitive hosts are carnivores, which are usually clinically
unaffected. They prey on the herbivorous intermediate hosts. Upon
being ingested by carnivores and released from mature cysts, zoites
invade the intestinal epithelium and develop into gamonts. Fertilization
occurs, followed by the formation of oocysts, which sporulate
within the carnivore's intestine. These infective oocysts are
shed in the feces. Susceptible herbivores then ingest oocysts
or sporocysts, and sporozoites are released in the intestine and
migrate into arterioles, where first generation merogony occurs
in endothelial cells. Merozoites released from these meronts undergo
second generation merogony in capillary endothelium throughout
the body. Upon subsequent liberation, these merozoites enter circulating
mononuclear cells and undergo endodyogeny (third generation merogony).
Finally, zoites from second and third generation meronts enter
the heart, skeletal muscle, or neural tissue (varies with species)
and develop into immature noninfective sarcocysts containing unicellular
metrocytes. These metrocytes produce bradyzoites that are infective
for the definitive host, and whose presence characterizes a mature
sarcocyst.3
Contributor: Department of Pathology and Microbiology, Faculty
of Veterinary Medicine, University of Montreal, P.O. Box 5000,
St. Hyacinthe, (Quebec), Canada J2S 7C6
References:
- 1. Jeffrey M: Sarcocystosis in sheep. In Practice, Jan 93:2-7.
- 2. Hulland TJ: Muscle and Tendon. In: Pathology of Domestic
Animals, 4th edition, Academic Press, Inc., San Diego, CA, Jubb
KVF, Kennedy PC, Palmer N, eds., vol. 1, pp. 256-259, 1993.
- 3. Gardiner CH, Fayer R, Dubey JP: An Atlas of Protozoan
Parasites in Animal Tissues, USDA-ARS, Agriculture Handbook No.
651, pp. 40-45, 1988.
International Veterinary Pathology Slide Bank:
Laser disc frame #13666-68, 13677, 15217, 21461
Case II - A96-323 (AFIP 2593931); one photo
Signalment: 35-year-old, male, chimpanzee (Pan troglodytes).
History: This animal was owned by a local private zoo,
euthanized and presented for necropsy with history of chronic
intermittent diarrhea and recent severe anorexia and weight loss
that was nonresponsive to therapy.
Gross Pathology: The postmortem interval was 12-15 hours.
There was minimal subcutaneous and intra-abdominal adipose tissue.
There was moderate and diffuse mesenteric and visceral lymph node
enlargement. There were 10-20 multifocal 0.2-2.5 cm, white, raised
papillary foci within the proximal duodenum. The pancreas was
small and firm. The duodenal and proximal to midjejunal mucosa
was thickened and segmentally reddened. The distal colonic mucosa
was segmentally reddened. The liver was friable and had a slightly
increased lobular pattern. The gallbladder was moderately distended
and the contents were opaque. The kidneys were unremarkable. There
was moderate to marked generalized muscle atrophy.
Laboratory Results:
4 days ante mortem 1 day ante mortem Human Male* Units
CHEM PANEL
Glucose 79 77 65-120 mg/dl
BUN 87 90 8-25 mg/dl
Creatinine 12.3 14.0 0.4-1.5 mg/dl
Phosphorus 6.8 5.1 2.5-4.5 mg/dl
Calcium 8.2 8.1 8.5-10.5 mg/dl
Total Prot. 8.0 6.4 6.0-8.0 g/dl
Albumin 3.4 2.5 3.5-5.1 g/dl
Globulin 4.6 3.9 1.0-3.5 g/dl
A/G 0.7 0.6 1.5-3.5
Sodium 132 132 135-145 mEq/L
Chloride 92 98 96-110 mEq/L
Potassium 3.9 2.1 -- mEq/L
CO2 19 16 20-30 mEq/L
AGAP 21.0 18.0 --
Tot. Bili. 0.90 0.35 0.01-1.20 mg/dl
Alk. Phos. -- 205 30-115 IU/L
GGT -- 12 0.0-41 IU/L
ALT 143 201 0-55 IU/L
AST 264 744 3.5-5.2 IU/L
LDH 2027 1620 110-225 IU/l
Cholesterol 279 196 100-200 mg/dl
Triglyceride 322 239 50-190 mg/dl
Amylase 9 8 15-105 IU/L
Na/K 34 63 --
CBC
|
Parameter |
4d b/f death |
1d b/f death |
Normal Range |
|
WBC |
14.3 |
11.1 |
3.9-10.6 x 103/ul |
|
RBC |
5.61 |
4.77 |
4.4-5.9 x 106ul |
|
Hemoglobin |
13.9 |
12.2 |
13.3-17.7 g/dl |
|
Hematocrit |
45 |
42 |
39.8-52.2 % |
|
MCV |
81.2 |
76.7 |
81-100 fl |
|
MCH |
24.8 |
25.6 |
26.6-33.8 pg |
|
MCHC |
30.9 |
25.6 |
31.5-36.3 g/dl |
|
Seg. Neut. |
9.724 (68%) |
7.548 (68%) |
1-8-7.0 x 103/ul |
|
Band Neut. |
1.143 (1%) |
-- |
0.0-0.7 x 103/ul |
|
Lymp. |
3.289 (23%) |
2.775 (25%) |
1.1-4.8 x 103/ul |
|
Mono. |
0.715 (5%) |
0.555 (5%) |
0.0-0.8 x 103/ul |
|
Eosino. |
0.429 (3%) |
0.222 (2%) |
0.0-0.4 x 103/ul |
|
Platelets adequate clumped but adequate adequate
|
Comment: moderate lipemia slight hemolysis
moderate hemolysis slight poikilocytosis
rouleaux present slight anisocytosis
*Upper and lower reference limits for adult male human
Direct fecal exam: No parasites seen
Fecal Giardia ELISA test: Negative
Fecal aerobic culture: No Salmonella, Shigella, or Campylobacter
species isolated.
Fecal anaerobic culture: No Clostridium species isolated.
Contributor's Diagnosis and Comments: Pancreas: Severe
chronic diffuse pancreatic exocrine atrophy and fibrosis.
Additional diagnoses (tissue not provided):
Skeletal Muscle: Moderate chronic multifocal muscle fiber atrophy.
Duodenum: Multiple adenomatous polyps.
Intestine: Moderate chronic multifocal eosinophilic enteritis
with intralesional nematodes (Enterobius vermicularis)
Liver/Gallbladder: Mild chronic diffuse lymphocytic and plasmacytic
cholangitis.
Moderate multifocal hepatocellular fatty change.
Kidney: Mild chronic multifocal interstitial nephritis.
Heart: Moderate chronic multifocal myocardial fibrosis.
Histologic examination of the pancreas revealed diffuse acinar
cell atrophy and loss. The remaining pancreas is composed primarily
of variably sized aggregates of islet cells intermixed with pancreatic
ducts surrounded by a moderately cellular fibrous connective tissue.
There are a few scattered foci of fat necrosis and variable scattered
collections of lymphocytes and plasma cells. The diffuse atrophy
and fibrosis are most likely sequelae to chronic pancreatitis.
The clinical pathologic findings of a marked increase in serum
creatinine, phosphorus, and BUN in the presence of a slight metabolic
acidosis are suggestive of significant renal disease; however,
the histologic findings indicate only mild renal disease. The
azotemia is presumed to be predominantly prerenal and a result
of decreased renal perfusion. The marked elevation in creatinine
is out of proportion to the elevation in BUN and in the absence
of significant renal disease may be a result of the lipemia and/or
hemolysis, or may be further falsely increased because of noncreatinine
chromogens such as ketones from the massive protein catabolism.
The observed cardiac fibrosis suggests that cardiac output may
have been altered and may have contributed to the reduction in
renal perfusion. The very low amylase may reflect the massive
loss of acinar tissue.
Chronic pancreatitis can have a variable presentation and most
dogs and cats have a history of chronic weight loss in the presence
of a vigorous appetite. In humans it can present as repeated attacks
of mild to moderately severe abdominal pain or persistent and
intractable abdominal pain. In some cases the local disease may
be clinically silent until either exocrine pancreatic insufficiency
(EPI) or diabetes develops. There are no consistent hematologic
or serum chemistry profile changes in EPI; the serum amylase and
lipase values are frequently within normal ranges, and undigested
fats are not consistently found in the feces; thus the diagnosis
of chronic pancreatitis requires a high index of suspicion. The
definitive test for EPI in dogs and cats is to measure serum trypsin-like
immunoreactivity.
- The pathogenesis of chronic pancreatitis is varied, and the
distinction between acute and chronic pancreatitis remains blurred.
Some inciting causes of pancreatitis in humans include alcoholism,
biliary tract disease, hypercalcemia, hyperlipidemia, pancreas
divisum (anomalous ductal system and stenosis of the duodenal
papilla), familial and hereditary factors.
-

- Case 11-2. Pancreas. Diffuse atrophy and fibrosis
of the exocrine glands.
- AFIP Diagnoses:
- 1. Pancreas: Atrophy, exocrine tissue, diffuse, severe, with
fibrosis and minimal multifocal lymphocytic pancreatitis, chimpanzee
(Pan troglodytes), primate.
- 2. Peripancreatic adipose tissue: Necrosis, multifocal.
Conference Note: As the contributor noted, measurement
of trypsin-like immunoreactivity (TLI) has become established
as the method of choice for diagnosing exocrine pancreatic insufficiency
(EPI) in the dog. This test measures trypsinogen, which is synthesized
exclusively by the pancreas. The serum level depends on pancreatic
mass, so pancreatic atrophy leads to reduced serum levels. In
cats, recent studies have demonstrated decreased serum TLI with
EPI; however, diagnostic criteria have not been established for
this species.5 False-negative results for EPI can occur with concurrent
pancreatitis and with renal failure.4
Other serum tests sometimes used to diagnose EPI include the
BT-PABA test and measurements of cobalamin and folate. In EPI,
folate is increased and cobalamin is decreased. However, false
positive results can occur due to bacterial overgrowth, which
causes a similar change in levels of these vitamins. With severe,
diffuse small intestinal disease, both values are decreased.4
The BT-PABA test indirectly measures chymotrypsin levels, which
are decreased in cases of EPI.
Contributor: Department of Comparative Pathology, New England
Regional Primate Research Center, Harvard Medical School, One
Pine Hill Drive, P. O. Box 9102, Southborough, MA 01772
- References:
- 1. Willard MD: Gastrointestinal, Pancreatic, and Hepatic
Disorders. In: Small Animal Clinical Diagnosis by Laboratory
Methods, Willard MD, Tvedten H, Turnwald GH, W. B. Saunders,
Philadelphia, PA, pp. 189-228, 1989.
- 2. Crawford JM, Cotran RS: The Exocrine Pancreas. In: Robbins
Pathologic Basis of Disease, 5th edition, Cotran RS, Kumar V,
Robbins SL, eds., W. B. Saunders, Philadelphia, PA, pp. 902-904,
1994.
- 3. Nelson RW, Couto CG: Essentials of Small Animal Internal
Medicine. Mosby Year Book, Boston, pp. 439-443, 1992.
- 4. Duncan JR, Prasse KW, Mahaffey EA: Veterinary Laboratory
Medicine, 3rd edition, Iowa State University Press, Ames, IA,
pp. 152-159, 1994.
- 5. Steiner JM, Williams DA: Feline exocrine pancreatic disorders:
insufficiency, neoplasia, and uncommon conditions. Comp Cont
Ed Pract Vet 19(7):836-849, 1997.
International Veterinary Pathology Slide Bank:
Laser disc frame #6581-2, 6627-8.
Case III - 96-2966 (AFIP 2594687)
Signalment: 3-day-old, male, Golden Retriever cross,
dog (Canis familiaris)
History: The pup was one of 8 in a litter from a Golden
Retriever cross bitch, heterozygous for Golden Retriever muscular
dystrophy (GRMD). From birth the pup was unable to suckle from
the bitch and, unlike its littermates, failed to gain weight.
Despite supplementary feeding the pup died at 3 days of age.
Gross Pathology: The trapezius, diaphragm, sternocephalicus,
abdominal muscles and tongue showed white streaking throughout
the length of the muscles. There was an acute aspiration bronchopneumonia.
Laboratory Results: Serum creatine kinase at 1 day old:
306,200 U/L
Genomic amplification of canine dystrophin gene exon 7-specific
polymerase chain reaction products (harvested from blood) identified
the point mutation in the consensus splice acceptor site in intron
6 of the canine dystrophin gene associated with Golden Retriever
muscular dystrophy (GRMD) (R.J.Bartlett et al 1996).
Contributor's Diagnosis and Comments: Skeletal muscle,
tongue: Severe, diffuse, polyphasic muscle necrosis and regeneration,
Golden Retriever cross, canine.
Etiology: X-linked inherited dystrophin deficiency: GRMD
Cardiac Muscle: No abnormality.
Heart: No abnormality detected.
Tongue: There were few areas of normal striated muscle within
the tongue. Variation in fiber size associated with muscle degeneration
and regeneration was a prominent feature. Degenerate muscle fibers
appeared swollen with increased eosinophilia, whereas regenerating
muscle fibers were narrow with variable cross sectional diameter
and occasional central nuclei. Evidence of muscle regeneration
was also demonstrated by prominent clusters of plump myonuclei
lining up along the edge of myofibers.
Segmental necrosis of muscle fibers was often accompanied by
increased basophilia due to mineralization. Areas of increased
tissue basophilia were associated with infiltrates of macrophages
and skeletal muscle precursor cells associated with myofiber regeneration.
GRMD is a genotypic and phenotypic homologue of Duchenne muscular
dystrophy (DMD) (B.J Cooper et al 1988). In both humans and dogs
with dystrophin deficiency there is phenotypic variation in the
clinical progression of the disease between individuals. One manifestation
of dystrophin deficiency recorded in dogs is a lethal neonatal
form (J.McC Howell et al 1994; B.A Valentine et al 1988). Pups
presenting with this form of the disease usually have serum creatine
kinase levels greater than 1000 times the normal adult range at
birth, and die before 14 days of age (B.A Valentine et al 1988;
J.McC Howell et al 1994). At post mortem there is severe muscle
necrosis and mineralization consistently involving the diaphragm
and intercostal muscles (J.McC Howell et al 1994). Muscles severely
affected by necrosis and mineralization in this pup included the
tongue, trapezius, intercostal and sternocephalicus muscles. Cardiac
lesions are usually absent until after 3 months of age (B.A Valentine
et al 1989).
- The presence of a range of degenerative and regenerative
stages within the skeletal muscle of the tongue at 3 days of
age indicates muscle necrosis associated with GRMD can occur
in utero. These features are consistent with the progression
of clinical disease documented by Valentine et al 1988.
-

- Case 11-3. Tongue. Note clusters of small round regenerating
muscle fibers. Degenerate (hyalinized) muscle fibers are occasionally
lined by myocyte nuclei (nuclear rowing) and separated by endomysial
fibroplasia.
- AFIP Diagnoses:
- 1. Tongue, skeletal muscle: Degeneration and necrosis, diffuse,
severe, with endomysial fibrosis, myocyte regeneration, and mild
lymphohistiocytic inflammation, Golden Retriever cross, canine.
2. Heart: No significant lesions.
Conference Note: The normal function(s) of dystrophin,
and the mechanism by which dystrophin deficiency results in cardiac
and skeletal muscle degeneration, are not known. This protein
is most abundant in skeletal, cardiac, and smooth muscle cells,
and is linked to an integral membrane glycoprotein. Valentine
et al suggest that it is a cytoskeletal protein, possibly involved
in membrane stabilization.
In addition to the canine model presented here, a murine mutant,
mdx, is also X-linked and lacks dystrophin, and thus is considered
to be an animal model for DMD. Although histopathologic changes
in both models are similar, the mdx mouse develops little or no
detectable weakness, so it is a poor clinical model for DMD.2
Contributor: School of Veterinary and Biomedical Sciences,
Murdoch University, Murdoch, Western Australia, 6150
- References:
1. Bartlett RJ, Winand NJ, Secore SL, Singer JT, Fletcher S,
Wilton S, Bogan DJ, Metcalf-Bogan JR, Bartlett WT, Howell JM,
Cooper BJ, Kornegay JN: Mutation segregation and rapid carrier
detection of X-linked muscular dystrophy in dogs. Am J Vet Res
57 (5): 650-4, 1996.
- 2. Cooper BJ, Winand NJ, Stedman H, Valentine BA, Hoffman
EP, Kunkel LM, Scott MO, Fischbeck KH, Kornegay JN, R. J. Avery,
et al: The homologue of the Duchenne locus is defective in X-linked
muscular dystrophy of dogs. Nature 334: 154-6, 1988.
- 3. Howell JM, Kakulas BA, Pass DA, Genovese L, Johnson R,
Lloyd F, Hobley WE: The fulminating neonatal form of expression
in the golden retriever dog model of Duchenne muscular dystrophy.
Muscle & Nerve; Supplement 1: S182, 1994.
- 4. Valentine BA, Cummings JF, Cooper BJ: Development of Duchenne-type
cardiomyopathy. Morphologic studies in a canine model. Am J Pathol
135: 671-8, 1989.
- 5. Valentine BA, Cooper BJ, de Lahunta A, O'Quinn R, Blue
JT: Canine X-linked muscular dystrophy. An animal model of Duchenne
muscular dystrophy: clinical studies. J Neurol Sci 88: 69-81,
1988.
International Veterinary Pathology Slide Bank:
Laser disc frame #9137-8, 9142-3
Case IV - B1364 (AFIP 2589271)
Signalment: 5-year-old, female, Friesian, bovine.
History: Four of 200 pasture-fed dairy cows that had
been supplementally fed maize silage died a week after aborting
late term fetuses. Principal clinical signs included profuse vaginal
discharge and labored breathing for two days prior to death.
Gross Pathology: The submitting veterinarian described
patchy consolidation of all lung lobes, particularly in the ventral
aspect, and diffuse pulmonary congestion and edema. There was
recent fibrinous pleurisy and excessive straw-colored pleural
exudate that clotted on exposure to air.
Laboratory Results: Mortierella wolfii was cultured
from samples of fresh lung.
- Contributor's Diagnoses and Comments: 1. Acute fibrinonecrotic
broncho-interstitial pneumonia with thrombosis, infarction, and
intralesional fungal hyphae. 2. Acute fibrinous pleuritis.
Mortierella wolfii is a mucoraceous zygomycete that is the most
frequently diagnosed cause of mycotic abortion in New Zealand
in dairy cattle. In such cases, the cow develops post-abortion
pneumonia. The organism has a restricted distribution in the
farming environment, preferring an aerobic, moist situation with
a substrate of pH 7.0 to 8.0, conditions provided most often
in spoiled silage.
-
- Case 10-4. Lung. Necrotic vessel contains numerous
hyphae with non-parallel sides, consistent with a zygomycete.
40X
- AFIP Diagnosis: Lung: Pneumonia, fibrinonecrotic,
acute, diffuse, severe, with necrotizing vasculitis, thrombosis,
pleuritis, and fungal hyphae, Friesian, bovine.
Conference Note: When the infected placenta separates
from the uterine attachments, hematogenous dissemination of fungi
occurs. Widespread growth of fungal hyphae occurs in pulmonary
capillaries and larger blood vessels, resulting in necrotizing
vasculitis and thrombosis, which leads to infarction and necrosis
of pulmonary parenchyma.
Other fungi within the phylum Zygomycota, primarily Mucor and
Rhizopus species, can also opportunistically invade the lung and
cause similar lesions. Likewise, several species of Aspergillus,
in the phylum Ascomycota, can cause severe acute pulmonary lesions
in mammals and birds. Although there are morphologic differences
in the various groups of fungi, definitive etiologic diagnosis
requires fungal culture, immunohistochemistry, or molecular techniques.
Contributor: New Zealand Registry of Animal Pathology, Batchelar
Animal Health Laboratory, P.O. Box 536, Palmerston North, New
Zealand
- References:
- 1. Cordes DO, Carter ME, diMenna ME: Mycotic pneumonia and
placentitis caused by Mortierella wolfii. II. Pathology of experimental
infection of cattle. Veterinary Pathology 9, 190-201, 1972.
- 2. diMenna ME, Carter ME: The identification of Mortierella
wolfii isolated from cases of abortion and pneumonia in cattle
and a search for its infectious source. Research in Veterinary
Science 13:439-442, 1972.
- 3. Dungworth DL: The Respiratory System. In: Pathology of
Domestic Animals, 4th edition, Jubb KVF, Kennedy PC, Palmer N,
eds., Academic Press, vol. 2, 665-667, 1993.
International Veterinary Pathology Slide Bank:
Laser disc frame #15642
Terrell W. Blanchard
Major, VC, USA
Registry of Veterinary Pathology*
Department of Veterinary Pathology
Armed Forces Institute of Pathology
(202)782-2615; DSN: 662-2615
Internet: blanchard@email.afip.osd.mil
* The American Veterinary Medical Association and the American
College of Veterinary Pathologists are co-sponsors of the Registry
of Veterinary Pathology. The C.L. Davis Foundation also provides
substantial support for the Registry.
Return to WSC Case Menu.